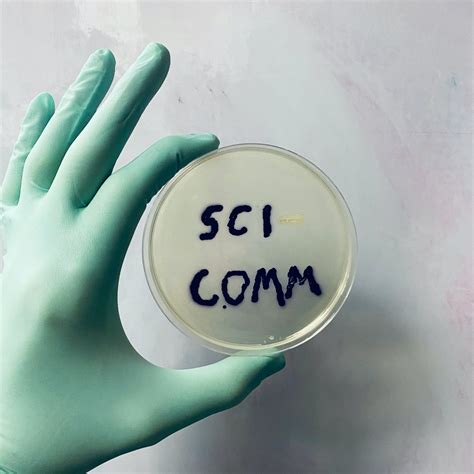

Effective Science Communication: Engaging The Public
Effective Science Communication: Engaging the Public
Hey guys! Ever wondered how scientists share their awesome discoveries with the rest of the world? That’s where science communication comes in! It’s all about making complex scientific topics easy to understand and interesting for everyone, not just those in lab coats. In this article, we’ll dive into why it’s so important, how it works, and some cool tips for doing it well.
Table of Contents
Why is Science Communication Important?
Science communication plays a critical role in bridging the gap between scientific research and the general public. Think about it: scientists are constantly making new discoveries that can impact our lives, from medicine and technology to environmental conservation. But if these findings stay locked away in scientific journals, how can they benefit society?
Informing the Public: First off, science communication keeps everyone informed. By translating complex research into easy-to-understand language, it empowers people to make informed decisions about their health, lifestyle, and the world around them. For example, understanding the science behind climate change can motivate individuals to adopt more sustainable practices. Similarly, knowing how vaccines work can ease concerns and encourage people to get vaccinated, protecting themselves and their communities.
Building Trust: Effective science communication can also build trust between scientists and the public. When scientists are transparent about their methods and findings, it shows they’re accountable and credible. This trust is super important for securing funding for research and for implementing science-based policies. In a world where misinformation spreads rapidly, having trustworthy sources of scientific information is more crucial than ever.
Inspiring Future Generations: Science communication isn’t just about explaining facts; it’s also about sparking curiosity and inspiring the next generation of scientists and innovators. When young people see how science can solve real-world problems and improve lives, they’re more likely to pursue STEM (science, technology, engineering, and mathematics) careers. Think about how a captivating science documentary or a cool museum exhibit can ignite a lifelong passion for discovery!
Promoting Evidence-Based Decision-Making: Science communication helps promote evidence-based decision-making at all levels, from personal choices to government policies. When policymakers have access to clear and accurate scientific information, they can make better decisions that are grounded in evidence rather than ideology. This is particularly important when addressing complex issues like public health crises, environmental regulations, and technological advancements.
How Does Science Communication Work?
So, how do scientists and communicators actually translate complex science for the masses? It’s a mix of different methods and skills , all aimed at making science accessible and engaging.
Simplifying Complex Information: The first step is to break down complex scientific concepts into smaller, more manageable pieces. This involves avoiding jargon, using analogies and metaphors, and focusing on the key takeaways. Instead of diving into technical details, communicators highlight the relevance and impact of the research. For example, explaining gene editing might involve comparing it to using software to edit a document, making it easier for people to grasp the basic idea.
Using Storytelling: Storytelling is a powerful tool for making science more relatable. By framing scientific information within a narrative, communicators can capture people’s attention and make the content more memorable. This might involve telling the story of a scientist’s journey, highlighting the challenges they faced and the breakthroughs they achieved. Or it could involve showing how a particular scientific discovery has improved the lives of real people.
Choosing the Right Medium: Science communication happens through various channels , each with its own strengths and weaknesses. Traditional media, like newspapers and TV, can reach a broad audience but may have limited space or time for in-depth explanations. Social media platforms, like Twitter and Facebook, offer the opportunity for interactive discussions and real-time updates, but they can also be breeding grounds for misinformation. Other options include blogs, podcasts, documentaries, museum exhibits, and public lectures. The key is to choose the medium that best suits the message and the target audience.
Engaging with the Audience: Effective science communication is a two-way street. It’s not just about broadcasting information; it’s about engaging with the audience and creating a dialogue. This might involve asking questions, encouraging feedback, and addressing concerns. It also means being responsive to comments and criticisms, and being willing to correct any errors. By engaging with the audience, communicators can build trust and foster a sense of shared understanding.
Tips for Effective Science Communication
Alright, you’re keen to communicate science effectively , right? Here are some tips to help you ace it:
Know Your Audience: Understanding your audience is crucial . Are you talking to kids, adults, policymakers, or scientists from a different field? Tailor your language, examples, and medium to suit their needs and interests. What might fascinate a group of experts could completely bore the general public, and vice versa.
Keep It Simple: Avoid jargon and technical terms as much as possible. Use everyday language and analogies to explain complex concepts. Imagine you’re talking to a friend who knows nothing about the topic – how would you explain it to them?
Be Clear and Concise: Get straight to the point . People have short attention spans, so make sure your message is clear, concise, and easy to follow. Use headings, bullet points, and visuals to break up the text and make it more digestible. A wall of text can be intimidating, so aim for clarity and brevity.
Tell a Story: Humans love stories . Frame your scientific information within a narrative to make it more engaging and memorable. Use real-life examples, anecdotes, and personal stories to bring the science to life. Think about how documentaries use storytelling to captivate viewers and make complex topics accessible.
Use Visuals: Images, videos, and infographics can be incredibly powerful tools for communicating science. They can help illustrate complex concepts, capture attention, and make the information more memorable. A well-chosen image can often convey more than words alone, so don’t underestimate the power of visuals.
Be Accurate: Accuracy is paramount . Always double-check your facts and sources to ensure that your information is correct. Misinformation can spread rapidly, especially online, so it’s important to be diligent about verifying your sources. If you’re not sure about something, it’s better to admit it and seek clarification than to spread false information.
Be Engaging: Make your content interactive and encourage participation . Ask questions, run polls, and solicit feedback. Use social media to start conversations and build a community around your topic. The more engaged your audience is, the more likely they are to remember and share your message.
Be Passionate: Let your enthusiasm shine through ! If you’re passionate about the topic, it will come across in your communication and make it more engaging for your audience. Share your excitement, explain why the science matters, and show how it can make a difference in the world. Passion is contagious, so let it inspire your audience.
Overcoming Challenges in Science Communication
Okay, science communication isn’t always a walk in the park. There are some hurdles we need to jump over.
Combating Misinformation: In today’s digital age, misinformation can spread like wildfire. It’s crucial to actively combat false or misleading information by providing accurate, evidence-based information. Fact-checking and debunking common myths are essential strategies for ensuring that the public has access to reliable information. Partnering with trusted sources and platforms can also help amplify accurate information and reach a wider audience.
Addressing Scientific Illiteracy: Many people lack a basic understanding of scientific concepts , which can make it difficult to communicate complex information effectively. To address this, communicators need to start with the basics and build a foundation of knowledge before delving into more advanced topics. Using simple language, analogies, and visuals can help bridge the gap and make science more accessible to a wider audience.
Dealing with Skepticism and Mistrust: Some people are naturally skeptical of science, especially if it challenges their beliefs or values. Building trust is essential for overcoming skepticism. This involves being transparent about the scientific process, acknowledging uncertainties, and addressing concerns honestly and respectfully. It also means listening to different perspectives and engaging in constructive dialogue.
Reaching Diverse Audiences: Science communication should be inclusive and accessible to all members of society . This means tailoring your message to different cultural backgrounds, languages, and levels of education. It also means using a variety of communication channels to reach different audiences. For example, some people may prefer to get their information from social media, while others may prefer traditional media or community events. Making science accessible to everyone requires a diverse and inclusive approach.
The Future of Science Communication
Looking ahead, the future of science communication is bright! With new technologies and approaches constantly emerging, there are endless opportunities to engage the public with science.
Virtual and Augmented Reality: VR and AR can create immersive and interactive experiences that bring science to life. Imagine exploring the human body in virtual reality or conducting a virtual chemistry experiment. These technologies have the potential to revolutionize science education and make learning more engaging and memorable.
Artificial Intelligence: AI can help personalize science communication and tailor it to individual needs and interests. AI-powered chatbots can answer questions, provide personalized recommendations, and facilitate interactive discussions. AI can also be used to analyze data and identify trends, helping communicators target their messages more effectively.
Citizen Science: Citizen science involves engaging the public in scientific research . This can range from collecting data to analyzing results. Citizen science projects empower people to contribute to real-world research and learn about science firsthand. They also foster a sense of ownership and engagement, making science more relevant and meaningful.
Collaboration and Partnerships: Effective science communication requires collaboration between scientists, communicators, educators, and policymakers. By working together, these stakeholders can leverage their expertise and resources to reach a wider audience and make a greater impact. Partnerships between universities, museums, and community organizations can also help promote science literacy and engagement.
So, there you have it! Science communication is super important for keeping everyone informed, building trust, and inspiring future generations. By using clear language, telling stories, and embracing new technologies, we can make science accessible and engaging for everyone. Let’s all do our part to spread the word and make the world a more scientifically literate place!